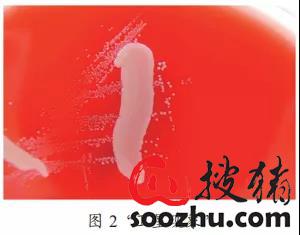
20211228030324660.jpg

饲料添加抗生素是养殖行业用来控制动物细菌病、促进畜禽生长的常用手段,随着人们公共安全意识的觉醒和提高,减抗、限抗和禁抗已是全世界养殖行业发展的大势所趋,替抗方案正受到越来越多的关注。副猪嗜血杆菌病是一种严重危害养猪业发展的细菌性疾病,近年来其发病率和死亡率呈逐年上升趋势。随着我国饲料禁抗新政正式落地,副猪嗜血杆菌病势必会以更猛烈的攻势掀起更大的风波。文章主要针对限抗背景下副猪嗜血杆菌病的防治措施进行了总结和分析,旨在为人们合理使用抗生素、选择替抗方案提供参考。
1 限抗背景
抗生素自20世纪20年代问世以来,便一直在人类和动物对抗感染性疾病的过程中发挥着重要作用,为人类和动物的健康成长保驾护航。随着畜牧业发展日趋集约化和规模化,抗生素一方面作为饲料添加剂常态化使用以促进畜禽生长、降低料重比;另一方面则在兽医临床上大量长期使用,以预防和治疗传染性疾病,降低畜禽患病率和死亡率。据世界卫生组织(WHO)统计,全球生产的抗菌药有50%用于养殖业。耐药菌的产生是一种自然现象,抗生素的广泛使用甚至滥用则加剧了这种现象的发展和传播,耐药菌株不断增多,耐药谱日益扩大,最终导致“超级细菌”出现(图1)。

第一,人类60%以上的病原菌来源于动物,动物源耐药菌可通过食物链传播给人,或将其耐药遗传物质转移给人体病原菌[2];第二,动物体内的残留兽药也可通过肉蛋奶进入人体,直接危害人类健康;第三,未被动物体吸收的抗生素由排泄物进入周围环境中,污染土壤和水源,导致环境中的耐药菌大量出现,耐药性进一步扩散。抗生素耐药性已严重威胁到畜牧业生产和公共卫生安全,给人类和动物健康带来安全隐患。
早在20世纪80年代,欧美等国家就意识到了动物源细菌耐药性问题,陆续采取了禁用抗菌药作为饲料添加剂的措施。WHO于2015年发布了《控制细菌耐药性全球行动计划》。我国于2016年开始启动了《遏制细菌耐药国家行动计划(2016-2020年)》和《遏制细菌耐药国家行动计划(2017-2020年)》;2019年7月农业农村部颁布了第194号公告,宣布从2020年1月1日起,停止生产、进口所有促生长类药物饲料添加剂,从2020年7月1日起,停止生产含有促生长类药物饲料添加剂的商品饲料。中国开始全面禁止促生长类药物在饲料中的添加使用,限抗行动正式拉开帷幕。
2 副猪嗜血杆菌介绍
副猪嗜血杆菌(Haomophilus parasuis,HPS)属于巴氏杆菌科,嗜血杆菌属,革兰氏阴性菌,镜下可见菌体呈现多种形态,从单个的短杆状到细长或丝状,通常具有荚膜。HPS为兼性厌氧菌,生长需要NAD,可在巧克力平板上生长,1~3d后长出大小不等的棕色到灰色菌落;或者在金黄色葡萄球菌存在的条件下在血琼脂平板上生长,呈“卫星现象”(图2)。需要液体培养时,可在补充了NAD和血清的TSB中生长。
HPS是条件致病菌,是上呼吸道的早期定植菌群之一,仔猪出生2d后即可在鼻腔内检测到该菌。HPS遍布全球猪场,在正常情况下不引起猪发病,但在应激条件(例如转群、降温、更换饲料、断奶等)或者免疫抑制性病原感染条件下,该菌可趁机侵入机体内部,引起全身性病变,包括多发性浆膜炎、胸膜肺炎、脑膜炎、心包炎、关节炎、败血症等。
HPS对任何年龄段的猪都致病,但主要影响2周龄~4月龄的猪,保育猪受影响最大。急性暴发时,小猪死亡率高达5%~10%。我国大部分猪场都有HPS发病记录,多为HPS和其他病原的混合感染,特别是猪蓝耳病(PRRS)、猪圆环病毒病2型(PCV2)、猪瘟等可以引起免疫抑制的病原。原发病原造成机体抵抗力下降,HPS伺机暴发加重感染,使疾病更加复杂难以治愈,死亡率增高。
HPS可分为15个血清型,另外还有20%以上的临床菌株不能分型。其中血清型1、5、10、12、13和14为强毒力菌株,血清型2、4、8和15为中等毒力菌株,血清型3、6、7、9和11为无毒力菌株。不同国家和地区流行的血清型存在差异,国内外大量调查数据显示血清型4、5和13是临床病例中最为常见的血清型(表1)。我国以血清型4和5最为常见,其次是13、14和12型。
3 副猪嗜血杆菌病临床症状和病理变化
HPS病的临床症状是非特异性的,包括发热、咳嗽、呼吸困难、关节肿胀、跛行以及中枢神经系统损伤症状,如震颤和划水样症状等(图3)。急性病例可见体表皮肤发红或苍白,四肢末端和耳梢发紫。慢性感染猪生长不良,被毛粗乱。剖检可见特征性病变——纤维素性多发性浆膜炎(图4)。心包、胸腔、腹腔和肺有明显纤维素性渗出物;心包膜与心脏粘连,伴有心包炎,严重时呈“绒毛心”;肺部肿胀,有不同程度出血,表面覆盖大量纤维素性渗出物,与胸腔粘连;关节腔内有大量黄色胶冻样黏液。

4 诊断
HPS的临床诊断必须与实验室方法(病原分离、PCR、免疫组化等)相配合,以排除其他能引起相似症状和病变的病原,如猪链球菌、猪鼻支原体、猪多杀性巴氏杆菌、猪胸膜肺炎放线杆菌和猪流感等。

PCR技术是目前HPS分子诊断最常用的技术,可直接用于病料检测,但在需要对菌株特性(抗药性、毒力鉴定和细菌分型等)进行补充时,建议进行菌株分离。HPS分离成功率不高,通常是采样和样品运输保存方式不合格、被其他病原菌生长掩盖等原因造成的。用于HPS分离的样品应来自出现明显全身性病变且未经抗生素治疗的猪只,要从不同器官(大脑、关节、浆膜表面等)和体腔(渗出液)采集以增加成功率。应注意HPS是上呼吸道的常在菌,猪只的鼻腔、扁桃体、气管和肺部并不适合采样进行诊断。采样需无菌操作,避免污染,并在低温条件(4~8℃)下尽快(<48h)送到实验室。
5 综合防控措施
副猪嗜血杆菌病是一种条件致病性疾病,它的防控必须从源头——生产管理做起,改善环境卫生条件、加强畜群饲养管理,提高猪群免疫力,减少应激,同时结合抗生素治疗和疫苗免疫才能获得理想效果。
5.1 改善环境卫生条件
确保猪舍清洁、地面干净,每天清理粪便、污水和剩料;每周对猪舍内外和猪场道路消毒,舍内带猪消毒时选择对人畜无害的消毒剂(如0.5%过氧乙酸、0.2%次氯酸钠等)并注意定期更换,猪舍外和道路则使用2%火碱或生石灰,消毒前需要彻底打扫和冲洗;严格执行人员、车辆、物料和饲料的消毒;加强舍内通风换气,保持空气新鲜和猪舍干燥,控制好猪舍内温度和湿度,减少冷热应激;做好灭鼠、灭蚊蝇和吸血昆虫工作。
5.2 加强畜群饲养管理
猪只分群管理,分段饲养,避免饲养密度过大;控制引种次数,引种前做好隔离检测再混群;不使用霉变饲料,对不同阶段的猪群选用不同配方饲料,注意营养均衡,发病时将病猪转出猪群集中护理,饲料以青饲料为主,有利于病猪康复;仔猪可以从母乳中获得抗体抵御HPS侵袭,应避免过早断奶。临床上PRRS、PCV2和HPS共感染的现象非常普遍,这两种病毒均可导致机体免疫抑制,使机体对其他病原的敏感性增强,导致继发感染,产生疾病叠加效应。因此,猪场应对上述两种常见的免疫抑制疾病进行免疫接种,可以帮助防控HPS病。
5.3 抗生素治疗
现阶段人们多选择抗生素来防治HPS病,临床上常用氨苄西林、氟喹诺酮类、头孢菌素、四环素、庆大霉素、磺胺类药物等。在使用抗生素治疗HPS病时需注意,在临床症状出现的早期,就必须对整个猪群大剂量注射抗生素进行治疗,保证全群用药而非仅针对出现临床症状的猪只。HPS进入浆膜、脑组织及关节后,由于这些部位血管分布少,抗生素难以到达发挥作用,因此对已经严重暴发HPS病的猪场,抗生素治疗的效果往往并不显著。此时抗生素应选用穿透性强、组织浓度分布高的药物。此外,HPS作为革兰氏阴性菌,死亡时会释放内毒素,导致机体发热,甚至休克死亡,基于此在药物疗效相近时,应尽量选择诱导细菌释放内毒素较少的药物,或者搭配解热镇痛的消炎药使用,以达到更好治疗的目的。
随着猪群对抗生素的依赖性不断增加,HPS耐药菌株也随之产生,并且耐药性强,变异速度快,多重耐药现象频现。国内外学者围绕HPS耐药性流行病学展开了调查(表2)。不同地区的HPS耐药情况有很大的不同,对同种药物也表现出不同的敏感性,这主要与当地侧重使用的抗菌药有关。因此,选择抗生素时不仅要参考文献资料报道的耐药性调查结果,最好能对本场的分离菌株进行药敏试验,根据药敏结果选择多种药物联合交替用药。

在HPS定植上呼吸道时使用抗生素会影响HPS的定植,进而干扰仔猪建立主动免疫,在致病性HPS侵入机体时丧失保护作用。抗生素的这种干扰作用不限于HPS,同样也作用于体内其他微生物菌群。研究表明,仔猪生命前期的微生物菌群定植对免疫系统的发育成熟是必需的,与仔猪的健康状态息息相关。抗生素对体内有益菌群同样具有抑制作用,在生命前期对仔猪用药会导致体内微生物菌群多样性下降,进而免疫系统功能下降。围产期间不使用抗生素,可提高仔猪断奶时鼻腔微生物菌群的总体多样性,其中Prevotella和Lactobacillus的菌群相对丰度增加,Moraxella和Bergeyella的相对丰度下降,仔猪保育期的生产性能和健康水平提高。因此,减少抗生素的使用,应是仔猪生产中优先考虑的事项。提高畜群管理水平和饲料质量,疫苗接种预防都是取代生猪生产过程中抗生素使用的有效方式。
综上所述,仅在特定情况下,一般是在疾病发生时,才建议采取策略性的抗生素治疗方法。日常应采取替代性控制措施,最大程度预防HPS病发生。
5.4 预防接种
5.4.1 母源抗体和母猪免疫接种
HPS病多发于2周龄到4月龄的中小猪,特别是断奶前后和保育期,因此需要对断奶仔猪重点管理,包括进行疫苗接种。HPS是仔猪出生后即入侵的早期定植菌群之一。仔猪出生后通过与哺乳母猪接触接受母猪体内携带的微生物菌群,同时也从初乳中获得母源抗体从而建立一个定植菌群与免疫力之间的动态平衡状态。母猪免疫可以有效降低仔猪发病率。Cerdà-Cuéllar等人发现接种商业化疫苗母猪的后代仔猪生命早期体内IgG抗体水平显著高于未免疫母猪的后代,在感染HPS的时间上也比后者延迟,感染程度更低,仔猪体内的HPS病原载量下降,定植HPS的血清型减少。免疫母猪所产仔猪在攻毒后产生肺部损伤和关节炎的比例显著下降,日增重显著高于未免疫母猪后代。分娩前免疫母猪可有效帮助仔猪抵御HPS病,在哺乳期保护仔猪,而母源抗体水平通常在仔猪3~4周龄时开始下降,在断奶前对仔猪接种可使仔猪断奶后也对HPS保持抵抗力。研究也表明,母源抗体的存在并不干扰仔猪断奶前的免疫接种。
5.4.2 主动免疫
目前报道的HPS疫苗种类有灭活疫苗、菌影疫苗、亚单位疫苗、DNA疫苗和减毒疫苗,在市面上流通的商业化疫苗则基本都是HPS灭活疫苗。HPS血清型分型众多,血清型分型抗原(多糖)和保护性抗原(外膜蛋白)成分不同,两者不能一一对应,各血清型之间甚至同种血清型之间的交叉保护力大小不一或者无交叉保护力。生产厂家通常选择对猪场所有菌株保护作用最广泛的菌株,将一种或几种血清型的HPS灭活后制成单价或多价疫苗。副猪嗜血杆菌血清1型和6型二价灭活苗可成功诱导针对血清型4和5的抗体,保护率分别达到100%和80%。
猪场也可在暴发HPS病后从病畜身上分离菌株制成自家苗使用。这种疫苗针对性强,但没有商品苗稳定,在一定时间内会使猪只机体处于强烈应激状态而导致抵抗力下降,如果灭活不彻底还会有散毒风险。各猪场制备自家苗时存在很多限制条件,应谨慎使用。
6 总结
近年来人们对食品和公共卫生安全的关注度愈发提高,国内饲料端禁抗、养殖端限抗是行业的大势所趋,也势必会对我国养殖业带来巨大影响。欧美国家禁抗限抗远早于我国,从他们的经验来看,饲料禁抗后,猪场的生产性能有所下降,尤其影响仔猪阶段以及一些生产管理水平低的猪场,防治成本增加。与欧美等国相比,我国的养殖管理水平较低、生态环境较差,病情更为复杂,禁抗带来的问题可能更为突出,损失可能更大,特别是仔猪阶段。HPS病是一种条件致病的细菌性疾病,限抗后暴发的概率也会大大提高,寻找替抗方案的需求相当迫切。欧美养殖企业在禁抗行动中最宝贵的经验就是养殖现场管理细节的改进和疫苗预防。提高饲养管理水平,减少疾病应激;改善畜舍环境条件,减少应激程度;提前免疫预防,控制病情发生和蔓延。在滥用抗生素带来的危害日趋显现的情况下,我国养殖从业者必须转变观念,对HSP以综合防控为主,管理为辅,配合疫苗免疫,从出生开始给仔猪提供保护,平稳度过限抗带来的起伏期,是现今养殖企业的最优选择。
(审核编辑: 猪猪侠)





















